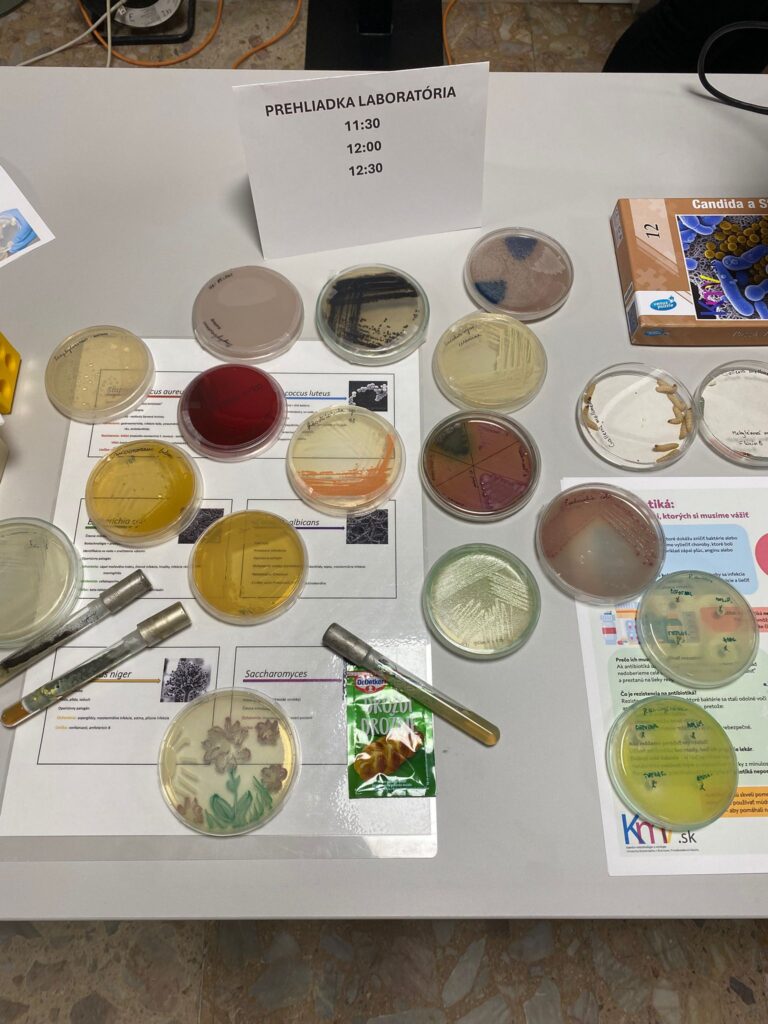

V piatok 6. februára 2026 sa konal na Prírodovedeckej fakulte UK „Deň otvorených dverí“. Tešíme sa, že sme sa aj my z Katedry mikrobiológie a virológie (KMV) mohli aktívne zúčastniť a prezentovať budúcim študentom nielen možnosti štúdia na našej katedre, ale aj aktuálne témy v rámci mikrobiologického a virologického výskumu, ktorým sa na katedre venujeme. Študenti mali veľký záujem aj o exkurzie do našich laboratórií, kde sme si pre nich pripravili praktické ukážky z každodennej práce mikrobiológa či virológa. Podujatie bolo organizované našou Prírodovedeckou fakultou a jeho cieľom bolo priblížiť štúdium na fakulte študentom, ktorých čaká dôležité životné rozhodnutie – akým smerom sa budú uberať po maturite?
Veríme, že prezentácia našej katedry ich motivovala a vyberú si pre svoje budúce štúdium našu fakultu a katedru. Vedec? Laboratórny diagnostik? Mikrobiológ regionálnych podnikov? Odborný pracovník pre oddelenie výroby vakcín? Manažér v distribučnej firme zaoberajúcej sa dodávkami pre výskumné laboratóriá? To všetko a ešte o mnoho viac môžete vykonávať ako absolvent štúdia na našej katedre.
Pevne dúfame, že sa nám podarilo potenciálnym záujemcom o štúdium zodpovedať všetky otázky a atraktívnym spôsobom predstaviť, čo je predmetom štúdia a výskumu na našej katedre.
Za kolektív KMV spracovala Jaroslava Dekkerová
Dňa otvorených dverí sa zúčastnili aj členovania riešiteľského kolektívu „FunBiof“ financovaného z EÚ NextGenerationEU prostredníctvom Plánu obnovy a odolnosti SR v rámci projektu č. 09I01-03-V04-00022.